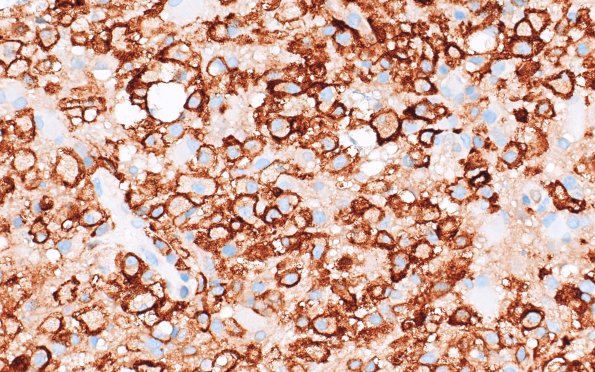
16E4 Inflammatory Demyelination (Case 16) CD163 40X 1

Table of Contents
Washington University Experience | MYELIN (IMMUNE-MEDIATED) | Inflammatory Demyelination | 16E4 Inflammatory Demyelination (Case 16) CD163 40X 1
CD163 demonstrates abundant and infiltrating macrophages/microglia in the demyelinated areas. (CD163 IHC)